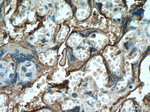
PLAP Antibody in Immunohistochemistry (Paraffin) (IHC (P))

Search
Proteintech
PLAP Monoclonal Antibody (2B7C9)
{{$productOrderCtrl.translations['antibody.pdp.commerceCard.promotion.promotions']}}
{{$productOrderCtrl.translations['antibody.pdp.commerceCard.promotion.viewpromo']}}
{{$productOrderCtrl.translations['antibody.pdp.commerceCard.promotion.promocode']}}: {{promo.promoCode}} {{promo.promoTitle}} {{promo.promoDescription}}. {{$productOrderCtrl.translations['antibody.pdp.commerceCard.promotion.learnmore']}}
产品信息
60294-1-IG
种属反应
宿主/亚型
分类
类型
克隆号
抗原
偶联物
形式
浓度
规格
纯化类型
保存液
内含物
保存条件
运输条件
产品详细信息
Immunogen sequence: SARQEGCQD IATQLISNMD IDVILGGGRK YMFRMGTPDP EYPDDYSQGG TRLDGKNLVQ EWLAKRQGAR YVWNRTELMQ ASLDPSVTHL MGLFEPGDMK YEIHRDSTLD PSLMEMTEAA LRLLSRNPRG FFLFVEGGRI DHGHHESRAY RALTETIMFD DAIERAGQLT SEEDTLSLVT ADHSHVFSFG GYPLRGSSIF GLAPGKARDR KAYTVLLYGN GPGYVLKDGA RPDVTESESG SPEYRQQSAV PLDEETHAGE DVAVFARGPQ AHLVHGVQEQ TFIAHVMAFA ACLEPYTACD LAPPAGTTDA AHPGRSVVPA LLPLLAGTLL LLETATAP (199-535 aa encoded by BC009647)
靶标信息
Placental Alkaline Phosphatase plays an important role in the regulation of specific inflammatory disease processes. There are at least four distinct but related alkaline phosphatases: intestinal, placental, placental-like, and liver/bone/kidney for this form of alkaline phosphatase have been well characterized. Placental Alkaline Phosphatase reacts with a membrane-bound isoenzyme (Regan and Nagao type) of Placental Alkaline Phosphatase (PLAP) occurring in the placenta during the 3rd trimester of gestation. Placental Alkaline Phosphatase is useful in the identification of testicular germ cell tumors. Unlike germ cell tumors, PLAP-positive somatic cell tumors uniformly express epithelial membrane antigen (EMA). A proposed function of Placental Alkaline Phosphatase is matrix mineralization; however, mice that lack a functional form of this enzyme show normal skeletal development. Placental Alkaline Phosphatase has been linked directly to hypophosphatasia, a disorder that is characterized by hypercalcemia and includes skeletal defects. The character of hypophosphatasia can vary, however, depending on the specific mutation since this determines age of onset and severity of symptoms.
仅用于科研。不用于诊断过程。未经明确授权不得转售。
生物信息学
蛋白别名: Alkaline phosphatase placental type; Alkaline phosphatase Regan isozyme; Alkaline phosphatase, placental type; alkaline phosphomonoesterase; Alp1; AP-TNAP; DOA1; FLJ11281; FLJ40094; FLJ61142; FLJ93059; Germ-cell alkaline phosphatase; glycerophosphatase; HOPS; Intestinal alkaline phosphatase; Intestinal-type alkaline phosphatase; MGC161443; MGC167935; nagao Isozyme; P PLAP; PLA2P; PLAA; Placental alkaline phosphatase 1; placental alkaline phosphatase precursor; placental heat-stable alkaline phosphatase; PLAP-1; PLAP1; preplacental alkaline phosphatase (EC 3.1.3.1); preplacental alkaline phosphatase type 1 (EC 3.1.3.1); Regan isozyme; TNAP; TNSALP; unnamed protein product
基因别名: ALP; ALPI; ALPP; IAP; PALP; PLAP; PLAP-1
UniProt ID: (Human) P05187
Entrez Gene ID: (Human) 250